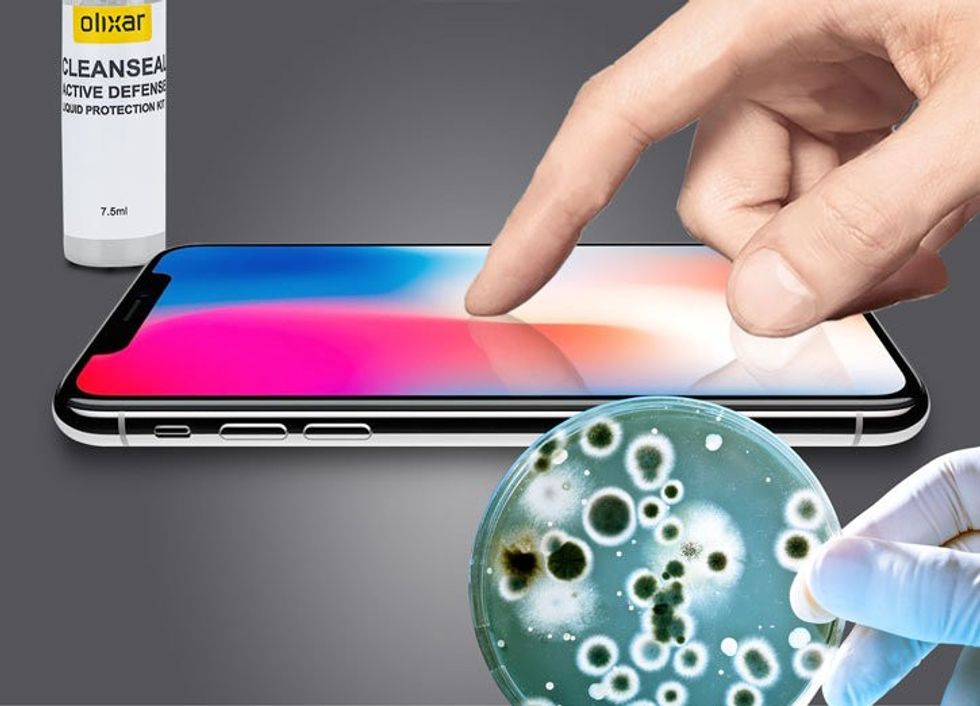
MISC protection

Nëse s’pastroni telefonin, kot që lani duart

Pasi kaloi vala e parë e panikut, jemi paksa më të qartë mbi masat që duhet të marrim për t’u ruajtur nga koronavirusi dhe bakteret
Gjëja më e rëndësishme është të lajmë duart me sapun dhe ujë të bollshëm për të paktën 20 sekonda. Mos harroni gishtat e mëdhenj, poshtë thonjve dhe kyçet.
E gjithë kjo punë është natyrisht e çuar dëm nëse me duart e pastra prekim telefonin që ka qenë në tavolinën e lokalit, në dysheme, në xhep, në çantë, në duart e të tjerëve.
Prandaj për të parandaluar kalimin e baktereve nga telefoni sërish në duar, pastrojeni!
Apple rekomandon përdorimin e një pëlhure që pastron xhamat, si ajo që pastron syzet. Nëse keni iPhone 7 ose një version më të ri, mund të përdorni një rrobë të njomur në ujë me sapun pasi modelet e fundit janë rezistentë ndaj ujit.
Apple dhe Samsung këshillojnë të mos përdorim detergjentë në pastrimin e telefonave pasi mund të dëmtojnë mbulesën e ekranit. Por, nëse keni xham mbrojtës, letrat e lagura dezinfektuese nuk i bëjnë asnjë dëm ekranit real. Xhami mbrojtës mund të ndërrohet.
Nëse flisni shpesh në telefon, merrni në konsideratë përdorimin e kufjeve, që të mos e afroni aq shpesh pajisjen në fytyrë. Edhe kufjet duhen pastruar, natyrisht.
Mund të përdorni alkool, për sa kohë nuk e lagni kunjën dhe pjesën e kufjeve që futen në vesh.
Lani duart dhe pastroni telefonin! Meqë jeni këtu, ndërroni këllëfin e jastëkut.